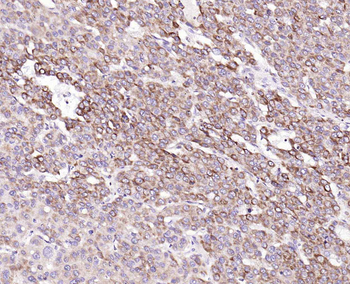
IL-8/CXCL8 Rabbit Polyclonal Antibody
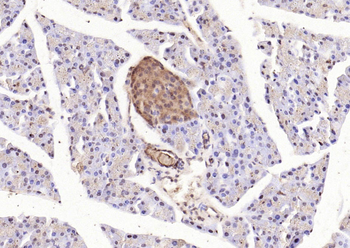
Phospho-STAT3 (Tyr705) Rabbit Polyclonal Antibody
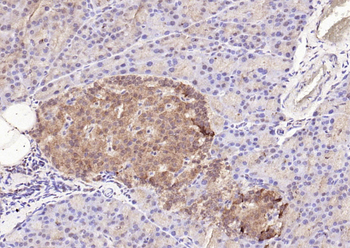
Phospho-STAT3 (Tyr705) Rabbit Polyclonal Antibody

You have no items in your shopping cart.
- Featured

ICC, IF, IHC-Fr, IHC-P, WB
Human, Mouse, Rat
Mouse, Rat
Rabbit
Recombinant
Unconjugated
100 μl, 25 μl, 50 μl - Featured

IF, IHC-Fr, IHC-P, WB
Human, Mouse, Rat
Mouse, Rat
Rabbit
Recombinant
Unconjugated
100 μl, 50 μl, 25 μl - Featured

FC, ICC, IF, IHC-Fr, IHC-P
Human, Mouse, Rat
Gallus, Porcine, Rabbit, Zebrafish
Rabbit
Polyclonal
Unconjugated
100 μl, 200 μl, 50 μl - Featured

ICC, IF, IHC-Fr, IHC-P
Human, Mouse, Rat
Gallus, Porcine, Rabbit
Rabbit
Recombinant
Unconjugated
25 μl, 100 μl, 50 μl - IL-8/CXCL8 Rabbit Polyclonal Antibody [orb10915]Featured

ELISA, WB
Human
Bovine, Porcine, Rabbit, Sheep
Rabbit
Polyclonal
Unconjugated
100 μl, 200 μl, 50 μl - CCR7 Rabbit Polyclonal Antibody [orb10276]Featured

FC, ICC, IF, IHC-Fr, IHC-P, WB
Human, Mouse, Rat
Canine
Rabbit
Polyclonal
Unconjugated
50 μl, 100 μl, 200 μl - Featured

WB
Mouse, Rat
Bovine, Canine, Guinea pig, Porcine, Rabbit, Sheep
Rabbit
Polyclonal
Unconjugated
100 μl, 200 μl, 50 μl - SARS-CoV-2 (COVID-19) Spike Antibody [orb1239976]
ELISA, IF, IHC, WB
Virus
Rabbit
Polyclonal
Unconjugated
0.1 mg, 0.02 mg - ACE2 Rabbit Polyclonal Antibody [orb704533]Featured

IF, IHC-Fr, IHC-P, WB
Human, Mouse, Rat
Mouse, Rat
Rabbit
Polyclonal
Unconjugated
100 μl, 200 μl, 50 μl - CD38 Recombinant Rabbit Monoclonal Antibody [orb704512]Featured

FC, ICC, IF, IHC-Fr, IHC-P, WB
Human
Rabbit
Recombinant
Unconjugated
25 μl, 100 μl, 50 μl